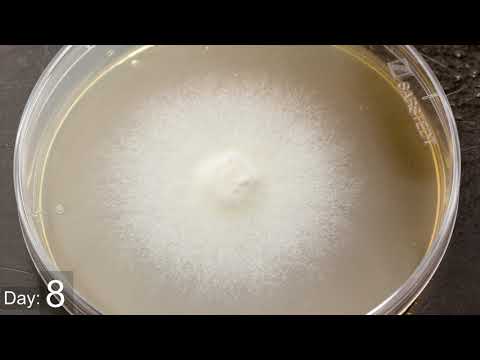
IMAGE_ALT

Mikko Tervala
Project repository of Mikko Tervala
Project Repository
Hi and welcome to my project repository!
Here you can find the hobby projects I work on during my free time.
Homelab network and server diagram
My home network and server diagram, including a fiber run to our neighbor and redundant DHCP and DNS
Home Automation
Home automatios that control most of our house
The Electric Longboard
An electric motor powered longboard, built completely from scratch
Automated Greenhouse
An automated watering system for crops
Hot Tub Thermostat
ESP-32 microcontroller based water thermostat with wireless bluetooth temperature sensor
Six channel LED dimmer PCB
Six channel PWM LED dimmer with ESP32 microcontroller used for home automation
DIY Fiber Internet
If your ISP won’t run fiber, do it yourself
Homelab Server
My server system for running services at home and for friends
YouTube Video - Tokyo Water VLOG
Humorous VLOG about purchasing water
YouTube Video - 10 Seconds of Content
A short video originated from not planning anything during vacation
YouTube Video - Mycelium growth of Flammulina velutipes
Final product produced by a student I was mentoring
Photography by me
Some of the best photos I have taken